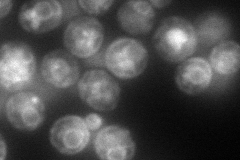
YMR214W
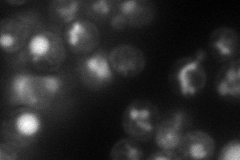
YMR214W

View description
One of several homologs of bacterial chaperone DnaJ, located in the ER lumen where it cooperates with Kar2p to mediate maturation of proteins
Localization:
Intensity:
Fold change:
Significance:
-
C’ GFP library in SD

ambiguous28.79 -
N' NOP1pr-GFP in SD
ER,punctate100.55 -
N' TEF2pr-mCherry in SD
ER,vacuole62.6766 -
N' NATIVEpr-GFP in SD

ER68.6399 -
N' TEF2pr-VC and Cyto-VN in SD

#N/A0 -
C’ GFP library in SD+DTT

ambiguous34.291.19No -
C’ GFP library in SD+H2O2

ambiguous29.671.03No -
C’ GFP library in Starvation Media

ambiguous19.280.66No -
C’ GFP library on the background of Pup2-DaMP

ambiguous -
C’ GFP library on the background of CCT mutant

ambiguous25.8210.89667No
